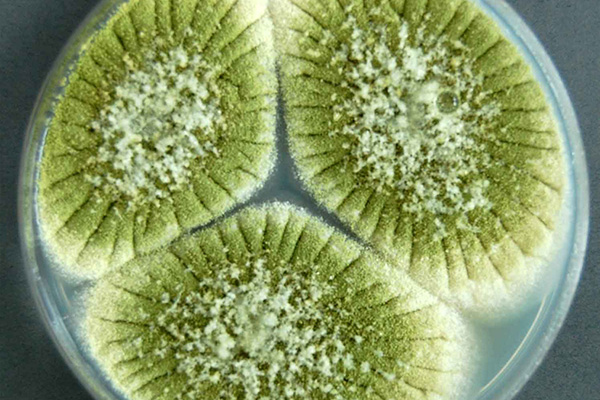

Alergólogo
¡Protege lo que más amas!
alergólogo pediatra

Dra. Palmira Delgado
Pediatría - Alergia e Inmunología Clínica
Alta especialidad en Inmunodeficiencias primarias
Experiencia:
- Licenciatura de Medicina en la Universidad Anáhuac Norte 2004-2010.
- Reconocimiento a la Excelencia Académica 2004 y 2005 otorgado por la Dirección Académica de la Universidad Anáhuac.
- Testimonio de Desempeño sobresaliente, obtenido en el Examen General para egreso de Licenciatura en Medicina General CENEVAL.
Especialidad realizada en el Hospital Infantil de México Federico Gómez, Universidad Autónoma de México 2010-2013.
- Subespecialidad realizada en el Hospital Infantil de México Federico Gómez, Universidad Nacional Autónoma de México 2013-2015.
- Reconocimiento al primer lugar en la evaluación del Programa Único de Especializaciones Médicas realizado por la UNAM 2014 y al segundo lugar en 2013.
- Reconocimiento al primer lugar en la evaluación escrita realizada por el Consejo Nacional de Certificación en Alergia e Inmunología Clínica.
Diplomado realizado en la Unidad de Inmunología del Politécnico Nacional, Agosto - Diciembre 2014. Ciudad de México.
International Observership Program, División de Alergia e Inmunología en el Children’s Hospital of Philadelphia, enero 2015.
Especialización realizada en el Instituto Nacional de Pediatría, Universidad Nacional Autónoma de México 2015- 2016.
Maestría orientada a la Investigación Clínica, Universidad Autónoma de México 2015 - 2017.
- Certificación por el Consejo Mexicano de Certificación en Pediatría. 2013 - 2018.
- Certificación por el Consejo Nacional de Certificación en Alergia e Inmunología Clínica. 2015 -2020.
- Trainee Member por Clinical Inmunology Society. Junio 2015.
- Certificación como Miembro Activo del Colegio Mexicano de Pediatrías Especialistas de Inmunología Clínica y Alergia. Julio 2015, Ciudad de México.
- Reconocimiento al primer lugar la evaluación realizada por el Consejo Nacional de Certificación en Alergia e Inmunología Clínica.
- Colegio Mexicano de Pediatras Especialistas en Inmunología y Alergia (COMPEDIA).
- Academia Americana de Alergia e Inmunología (AAAI) .
- Sociedad Latinoamericana de Inmunodeficiencias ( LASID) .
- Sociedad Inmunología Clínica (CIS).
- Sociedad Europea de Inmunodeficiencias (ESID).
Servicios
Te brindamos servicios especializados para garantizar tu bienestar y el de tu familia.

Pruebas cutáneas
Realizamos el diagnóstico de alergias mediante un método moderno, rápido e indoloro.
Las pruebas cutáneas para el diagnóstico de alergia, son realizadas con la finalidad de conocer qué alérgeno (sustancia del medio ambiente) produce una una reacción alérgica en el paciente.
Este método consiste en la aplicación de una pequeña cantidad de extracto de alérgeno en la piel (puede ser en parte superior de espalda o antebrazo) seguido de una ligera punción para que la sustancia se introduzca en la piel. Se prueban varios alérgenos al mismo tiempo.
Posteriormente se espera de 15 a 20 minutos para que se dé la interpretación de los resultados.
Las pruebas hace algunos años eran dolorosas y tomaban mucho tiempo, por lo que resultaban muy incómodas especialmente para los niños. Actualmente existe un método novedoso de multipunción que facilita la prueba y produce muy poco o ningún dolor.

Inmunoterapia
Alérgeno Especifica
La inmunoterapia es el único tratamiento que puede modificar la enfermedad alérgica.
Tratamiento de alta tecnología que brinda excelentes resultados en la modificación de la enfermedad alérgica de nuestros pacientes.
Consiste en administrar dosis crecientes del alérgeno al que el paciente es sensible, con el objetivo de disminuir los síntomas. Los alérgenos pueden ser administrados mediante inyecciones subcutáneas ó por vía sublingual, que como su nombre lo indica se administra debajo de la lengua, convirtiéndolo en un método menos agresivo y mejor tolerado.
La inmunoterapia mejora la calidad de vida de los pacientes que sufren enfermedades alérgicas tales como rinitis, asma e hipersensibilidad a insectos.
Además de bloquear la enfermedad, este tratamiento evita que aparezcan nuevas sensibilizaciones, disminuye la progresión al asma en caso de padecer rinitis y alivia los síntomas progresivamente.

Inmunoestimulantes
Recomendado para el tratamiento y prevención de infecciones respiratorias recurrentes.
El tratamiento con immunoestimulantes reduce el riesgo de las infecciones respiratorias agudas en el paciente.
En algunas ocasiones los pacientes presentan deficiencias en el sistema inmune, encargado de proteger al cuerpo de enfermedades; condicionando al paciente a un número mayor de infecciones.
Una vez realizada una valoración para descartar otra patología, se inicia el tratamiento donde administramos inmunoestimulantes desarrollados a partir de productos biológicos para estimular los mecanismos de defensa y la respuesta inmune.
Atención Pediátrica
Protegemos la salud y desarrollo de los más pequeños de la casa
Consulta
$1,200 MXN
Diagnóstico y tratamiento
Contamos con la más alta tecnología y amplia experiencia en el diagnóstico oportuno y tratamiento del asma, todos los tipos de alergias e inmunodeficiencias enfocadas en pacientes de todas las edades.
Cada uno de nuestros pacientes recibe atención personalizada e integral, lo que nos permite brindarle un tratamiento eficaz y que responde a las necesidades y características particulares de cada caso.
Adicionalmente, para mayor comodidad ofrecemos el servicio de Estudios de Laboratorio básicos (Biometria hematica + Química sanguínea + Inmunoglobulinas).
Asma
Rinitis alérgica
Conjutivitis alérgica
Alergia alimentaria
Urticaria
Alergia a insectos
Alergia a medicamentos
Dermatitis atópica
¿Padeces de alergia?
Prueba rápida de Influenza
En la actualidad es posible diagnosticar y tratar el virus de la influenza, sobre todo si se consulta al especialista cuando los síntomas comienzan. Para poder saber si un paciente está contagiado del virus se realiza una prueba diagnóstica cuyos resultados son entregados entre dos y tres días hábiles en los laboratorios convencionales.
Teniendo en cuenta lo importante que es obtener los resultados cuanto antes, ponemos a tu disposición y a la de toda tu familia, la prueba rápida para la detección del virus de influenza. El diagnóstico se realiza a través de un sistema de alta tecnología que permite realizar la prueba en el consultorio y dar los resultados en tan sólo 25 minutos y con un 97% de efectividad.
Resultados en
minutos
Garantizamos
de efectividad
Prueba cutánea
+
Consulta
$3,000 MXN
Preguntas frecuentes
Puedes contactarnos si tienes alguna inquietud adicional, con gusto aclararemos tus dudas.
Alérgenos comunes
Existen distintos alérgenos identificados que son los causantes de buena parte de los síntomas molestos, y a veces peligrosos, que afectan a muchos de nuestros pacientes.
Conoce algunos de los alérgenos responsables de las alergias:
Cuidamos a los más pequeños de la casa
Visítanos
TORRE GINECO-PEDIÁTRICA DALINDE
Visítanos
HOSPITAL SATÉLITE
¿Quieres estar al tanto de todos nuestros tratamientos?
Suscríbete al boletín de noticias para recibir información y promociones especiales para ti y tus seres queridos.
Reserva tu cita
¡Estamos aquí para ti y tu familia! Puedes contactarnos para cualquier duda o para agendar tu cita a través del siguiente formulario, al correo consultas@asma-alergia.com y a los siguientes teléfonos:
ASMA-ALERGIA, con domicilio en calle Tehuantepec 251, interior 101, Ciudad de Mexico, municipio o delegación Cuauhtémoc, c.p. 06760, en la entidad de Ciudad de Mexico, Mexico, es responsable de la seguridad y confidencialidad de los datos personales que usted voluntariamente nos proporciona, tiene el compromiso de proteger su privacidad y cumplir con la legislación aplicable a la protección de datos personales en posesión de los particulares. Con fundamento en los artículos 15º y 16º de la Ley Federal de Protección de Datos Personales en Posesión de Particulares (en los sucesivo denominada como “la ley”) hacemos de su conocimiento que ASMA-ALERGIA es responsable de recabar sus datos personales, del uso que le dé a los mismos y de su protección.
Los términos que se utilicen en el presente aviso de privacidad tendrán la definición que a los mismos le asigna la Ley Federal de Protección de Datos Personales en Posesión de Particulares publicada en el Diario Oficial de la Federación el 5 de julio de 2010. Este Aviso especifica el tipo de datos que ASMA-ALERGIA recolecta, los fines para los cuales lleva a cabo el tratamiento de los mismos, así como los derechos con que cuenta el titular al respecto.
FINALIDAD Y UTILIZACION DE SUS DATOS PERSONALES
Sus datos personales serán utilizados para las siguientes finalidades:
- Datos de identificación y contacto del paciente.
- Atención al cliente.
- Envío de estudios y resultados de laboratorio
- Envío de información necesaria y de interés para el paciente.
DATOS PERSONALES QUE OBTENEMOS Y DE DONDE.
ASMA-ALERGIA recopila la información a través de los datos que el usuario proporciona vía telefónica, vía correo electrónico, en el formulario de contacto que aparece en la parte inferior de la página web y a través de los mensajes privados en nuestra página oficial en Facebook y redes sociales.
La información obtenida se limita a datos generales de los pacientes, indispensables para brindarles la atención que requieren, como:
- Nombres
- Teléfono
- Correo electrónico
- Situación general que motiva la consulta.
Si eventualmente ASMA-ALERGIA obtuviera datos personales aparte de los mencionados, se seguirán los principios que establece la Ley Federal de Protección de Datos Personales: licitud, consentimiento, información, calidad, finalidad, lealtad, proporcionalidad y responsabilidad.
MEDIOS PARA EJERCER SUS DERECHOS ARCO
Es importante informarle que usted tiene derecho al Acceso, Rectificación, Cancelación y Oposición de sus datos personales, a oponerse al tratamiento de los mismos o a revocar el consentimiento que para dicho fin nos haya otorgado.
Los mecanismos que se han implementado para el ejercicio de dichos derechos son a través de la presentación de una solicitud en los términos que marca la ley en su Art. 29º a nuestro Departamento de Comunicaciones, a través del correo electrónico consultas@asma-alergia.com
Para que ASMA-ALERGIA pueda atender correcta y oportunamente cualquiera de las solicitudes a las que se refiere esta sección, la solicitud del titular deberá contener:
- Nombre del titular y domicilio y otro medio para comunicarle la respuesta.
- Descripción clara y precisa de los datos personales o instituciones respecto de los que desea ejercer sus derechos ARCO.
SALVAGUARDA DE LOS DATOS PERSONALES
ASMA-ALERGIA tiene implementadas las medidas de seguridad, técnicas, administrativas y físicas, necesarias para proteger sus datos personales y evitar su daño, pérdida, alteración, destrucción o el uso, acceso o tratamiento no autorizado.
Únicamente el personal autorizado, que ha cumplido y observado los correspondientes requisitos de confidencialidad, podrá participar en el tratamiento de sus datos personales. El personal autorizado tiene prohibido permitir el acceso de personas no autorizadas y utilizar sus datos personales para fines distintos a los establecidos en el presente Aviso de Privacidad. La obligación de confidencialidad de las personas que participan en el tratamiento de sus datos personales subsiste aun después de terminada la relación con ASMA-ALERGIA.
CAMBIOS AL AVISO DE PRIVACIDAD
ASMA-ALERGIA se reserva el derecho de efectuar en cualquier momento modificaciones o actualizaciones al presente aviso de privacidad, para la atención de políticas internas o nuevos requerimientos para la prestación y ofrecimiento de nuestros servicios.
Estas modificaciones estarán disponibles al público a través de la página web o vía correo correo electrónico.
En la medida que el titular no solicite, en los términos antes mencionados, la cancelación y/u oposición de sus datos personales y continúe accediendo y/o utilizando, parcial o totalmente, los Servicios, implicará que ha aceptado y consentido tales cambios y/o modificaciones.
Al proporcionarle sus datos personales a ASMA-ALERGIA, el titular expresamente reconoce y acepta el presente Aviso, según el mismo pueda ser modificado cuando sea necesario, y otorga su consentimiento para que ASMA-ALERGIA ejerza en el procesamiento de sus datos personales de la forma que se explica en el presente. Si el titular no acepta este Aviso, podrá ejercer los derechos que le confiere la Ley, según se describe anteriormente.